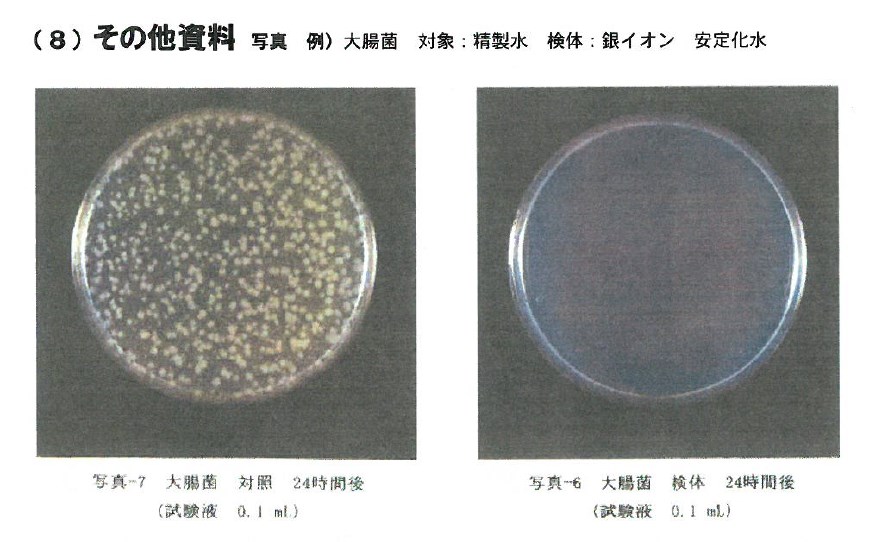
『Ag+銀イオン水とは』

ギフト&雑貨に関連する気になるカタログにチェックを入れると、まとめてダウンロードいただけます。
ブランドの認知拡大とは?課題と対策・製品を解説

目�的・課題で絞り込む
カテゴリで絞り込む
インポート |
おしゃれ雑貨 |
キャラクター・ライセンス・エンターテインメント |
パーソナルギフト・マイルーム・マイグッズ |
ホームファッショングッズ |
生活雑貨 |
美と健康 |

販促・キャンペーンにおけるブランドの認知拡大とは?
各社の製品
絞り込み条件:
▼チェックした製品のカタログをダウンロード
一度にダウンロードできるカタログは20件までです。
【ベビー用品向け】パッケージデザインにおける色の重要性
ダスキン レンタルサービス
ふせん付2色ボールペン『ひっぱる!ふせんペン』
手書きカラーLEDスタンド『コサインピクト』
芽が出る鉛筆
JE-BLW04 フィラメントLED電球 E17 昼白色
『Ag+銀イオン水とは』
生活雑貨
【カタログ】珪藻土製品『soil』(ダイジェスト版)
SDG's に貢献 環境配慮素材で育てる花の種ノベルティ
製品カタログ ホーロー製品
和紙 製造サービス
花の種付きポストカード ノベルティ(企業名印刷付)
土佐まき和紙
アトリグラス有限会社 輸入ガラスアイテム取扱カタログ
OEM/ODM雑貨企画・製造サービス
傘ホルダー『Casash』
【総合カタログ】ご家庭向けケミカル製品
高機能抗菌スプレー『バイオウォーター』ウイルス対策に活躍
【製品加工事例】枯山水をモチーフにしたお香立て『koniwa』
ライフスタイル製品『ZINIZ』総合カタログ
ROYAL 4040RCレーザー カットタオル
テクナード株式会社 会社案内
ひも付きポリ袋 半透明20枚
OEMグッズ 開発サービス
詰め替えパックをそのまま使える『詰め替えクリッピュ』
オリジナルギフト 製作サービス
雑貨 OEM生産サービス
オリジナル製品『ころころ募金箱』
オンラインショッピングモール『PsyPre』
OEMトイレットペーパー
【オリジナルグッズ製作】グッズやノベルティ製品などを受注制作
ノベルティグッズ・オリジナル製品
株式会社ネクストインターナショナル 製品紹介
【企業イメージ向上・ステークホルダーへPRに】幸せを広げるお菓子
安達紙器工業 製品カタログ
ペーパータオル『のん・しゅきん』
ピュアパルプ100%のキッチンペーパータオル
ブックマーカー
超撥水・防水 布用強力撥水剤
長年培ったモノづくりのノウハウで、高品質のノベルティーを供給!
雑貨OEM/ODM
4つのeco!環境にやさしいシューズクリーナー
追加料金0円 のし紙イラスト「ファミリー」
JE-BLY01 フィラメントLED電球 E26 電球色
ワインボトルリサイクル製品『funew』のご紹介
総合カタログ『印鑑ケース』
クラレトレーディング株式会社 ECサイトオープン
寄付付きノベルテ��ィ ブリックメモボーダレスアートデザイン
ベルクロ(R)ブランド ジザイ着脱テープ クリア薄型 91327

お探しの製品は見つかりませんでした。
1 / 2
販促・キャンペーンにおけるブランドの認知拡大
販促・キャンペーンにおけるブランドの認知拡大とは?
ギフト&雑貨業界における販促・キャンペーンのブランド認知拡大とは、自社ブランドの商品やサービスをより多くの潜在顧客に知ってもらい、記憶に残るようにするための活動全般を指します。これにより、購買意欲の向上やリピート購入、さらにはブランドロイヤリティの構築を目指します。
課題
ターゲット層へのリーチ不足
自社ブランドに関心を持つ可能性のある顧客層に、効果的に情報が届いていない状況です。特に新規顧客の獲得が難しい場合があります。
キャンペーン情報の埋没
競合他社も多数の販促活動を行っており、自社のキャンペーン情報が消費者の目に留まりにくく、埋もれてしまう傾向があります。
ブランドメッセージの希薄化
キャンペーンを通じて伝えたいブランドの個性や価値が、消費者に十分に伝わらず、印象に残りにくい状態です。
効果測定の難しさ
実施した販促・キャンペーンが、実際にどれだけブランド認知の拡大に貢献したのかを定量的に把握することが困難です。
対策
多角的な情報発信
SNS、インフルエンサーマーケティング、オンライン広告、店舗でのイベントなど、複数のチャネルを組み合わせ、ターゲット層に合わせた情報発信を行います。
魅力的なコンテンツ企画
限定ノベルティ、SNSでのプレゼント企画、体験型イベントなど、消費者の興味を引きつけ、参加したくなるようなユニークなキャンペーンを企画します。
ストーリーテリングの活用
ブランドの誕生秘話、商品のこだわり、作り手の想いなど�をストーリーとして伝え、感情に訴えかけることで、ブランドへの共感と記憶を促進します。
データに基づいた効果分析
ウェブサイトのアクセス解析、SNSのエンゲージメント率、アンケート調査などを活用し、キャンペーンの効果を測定・分析し、次回の施策に活かします。
対策に役立つ製品例
デジタル広告配信システム
特定のターゲット層に絞り込んだ広告配信が可能で、ブランド認知拡大に貢献する潜在顧客へのリーチを効率化します。
SNS運用支援ツール
投稿の予約、効果測定、競合分析などをサポートし、魅力的なコンテンツを継続的に発信することで、ブランドの存在感を高めます。
インフルエンサーマッチングサービス
ブランドイメージに合ったインフルエンサーを選定し、商品紹介やキャンペーン告知を依頼することで、フォロワーへの効果的な情報拡散を実現します。
顧客データ分析システム
購買履歴や行動履歴を分析し、顧客のニーズを把握することで、よりパーソナライズされたキャンペーンを展開し、ブランドへの関心を深めます。
⭐今週のピックアップ

読み込み中